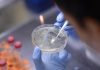
Nobel Medicina 2021, niente premio a scienziati vaccini Covid: cosa dicono esperti

(Adnkronos) –
Nicoletta Luppi, presidente e Amministratore delegato di Msd Italia, è stata nominata presidente dello Iapg – Italian american pharmaceutical group – il Gruppo che riunisce le aziende farmaceutiche italiane a capitale americano e costituisce una delle componenti all’interno di Farmindustria.
Laureata in Lingue e letterature moderne, con un Master in Business Administration presso la Luiss School of Management di Roma – si legge in una nota di Iapg – testimonial Amref per la campagna sulle mutilazioni genitali femminili, nonché membro di “Valore D”, la prima associazione di imprese che “promuove l’equilibrio di genere e una cultura inclusiva per la crescita delle Aziende e del Paese”, Nicoletta Luppi ha iniziato nel 1993 la sua carriera in Msd, ricoprendo negli anni diversi ruoli con crescenti responsabilità. Nel 2012, è stata nominata presidente e Amministratore delegato di Sanofi Pasteur Msd (la joint venture tra Sanofi Pasteur e la Divisione vaccini di Msd) e in tale ruolo è stata insignita del premio “Ceo of the Year” (Premio “Le Fonti”, Area Farmaceutica) ed è stata eletta presidente del Gruppo Vaccini Farmindustria.
Nel 2015, Nicoletta Luppi è tornata in Msd Italia nel ruolo di presidente e Ad. Nel 2019 – continua la nota – è stata inserita tra le “Businessperson of the Year” da Fortune Italia, nel 2021 tra i 100 Top manager di Forbes Italia e, nel 2022, nella classifica di Forbes Italia delle “100 Donne Vincenti”. Da luglio del 2022, Nicoletta Luppi è inoltre vicepresidente di Farmindustria e componente del suo Comitato di Presidenza.
“Sono orgogliosa e grata a tutti i membri dello Iapg – dichiara Nicoletta Luppi – per questa nomina di grande importanza e responsabilità. Mi preme sottolineare il grande contributo fornito al Sistema Paese dalle 15 aziende farmaceutiche americane che operano in Italia, soprattutto in termini di innovazione, investimenti in Ricerca e Sviluppo, occupazione ed export. Per le aziende statunitensi, l’Italia è il primo Paese dell’Unione europea in termini di produzione farmaceutica e il secondo per occupazione, con più di 13.000 addetti diretti e altrettanti nell’indotto: parliamo di un quarto degli addetti di tutto il settore farmaceutico in Italia”.
Negli ultimi 5 anni, nonostante un contesto globale complesso gravato dalla pandemia e, più recentemente, anche dal conflitto in Ucraina, gli investimenti americani nel settore farmaceutico in Italia hanno superato i 2 miliardi di euro, dei quali il 50% in investimenti in Ricerca & Sviluppo. Secondo i dati elaborati da Farmindustria, nel 2021 le aziende farmaceutiche americane hanno generato circa 6 miliardi di euro di fatturato, quasi un terzo dell’intero settore, e più di 4 miliardi di esportazioni.
“Per mantenere e migliorare questi risultati – sottolinea Luppi – sarà indispensabile proseguire il nostro dialogo con tutti i diversi stakeholder (Istituzioni a livello nazionale e regionale, società scientifiche, associazioni di pazienti e, certamente, Farmindustria guidata dal neo-eletto presidente Marcello Cattani), al fine di contribuire alla definizione di una nuova governance farmaceutica che riconosca il ruolo strategico dell’industria e valuti correttamente le risorse allocate alla farmaceutica come un investimento e non un costo, per favorire un rapido e omogeneo accesso alle cure, a beneficio dei pazienti e della sostenibilità del servizio sanitario. Obiettivi sfidanti che condivideremo con convinzione all’interno del rinnovato Comitato di presidenza di Farmindustria che, anche grazie alla rappresentanza Iapg tutta femminile (sarà infatti con me Emma Charles, General manager di Bms Italia), sarà orgogliosamente ancora più tinto di rosa”.
“Tutto questo lo faremo con una squadra agile, affiatata e pienamente inclusiva per dare il nostro contributo a vincere la sfida delle risorse e delle riforme – recentemente richiamata dal ministro Speranza – per preservare e rilanciare il nostro Servizio sanitario nazionale”, conclude.